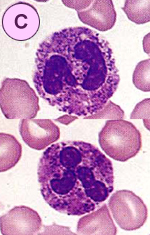

Q16. 好中球の形態所見について正しいものはどれですか。 解答と解説
PB-MG.X1000
![]() |
![]() |
|
|---|---|---|
![]() |
||
| 形態所見について | |
| 1 | 正常である。 |
|---|---|
| 2 | 細胞質に顆粒異常がみられる。 |
| 3 | 細胞質にデーレ小体がみられる。 |
| 4 | 核に形状異常がみられる。 |
| 考えられる疾患について | |
| 1 | 正常 |
|---|---|
| 2 | メイ・ヘグリン(May-Hegglin)異常症 |
| 3 | ペルゲル・ヒュエット(Pelger-Huet)異常症 |
| 4 | エルダー・レイリー(Alder-Reilly)異常症 |
| 5 | 類白血病反応 |
【ねらいと解説】
今回は白血球の形態異常を提示しました。
白血球の形態異常には先天性のものと後天性のものがあります。先天性には@核異常、A細胞質異常、
B顆粒異常に分けられます。核異常には遺伝性核過分葉症、ペルゲル・ヒュエト異常症があり、細胞質
異常にはメイ・ヘグリン異常症があり、顆粒異常にはエルダー・レイリー異常症、チェヂイアック・東異常症
があります。一方、後天性には敗血症や骨髄異形成症候群(MDS)、白血病などでみられますが、この場合
先天性と区別するために偽(pseudo)をつけて表現します。
A.はペルゲル・ヒュエット異常症にみられたもので、核の形状が円形、鼻メガネ状、ダンベル状を呈する
もので機能には異常がなく常染色体優性遺伝とされます。周囲の好酸球や好塩基球にも同様な形態異常
がみられました。
B.はメイ・ヘグリン異常症にみられたもので、好中球の細胞質に直径1〜2μmで卵円形また紡錘形の青味
を帯びた斑点がみられます。これは細胞質の成熟が遅れて部分的にリボゾーム(RNA)が残留したもの
とされこれをデーレ小体とよびます。本症は常染色体優性遺伝にみられるといわれ、他に血小板減少に伴
い巨大血小板(奇形)もみられます。後天性では重症感染症、火傷、MDSなどでみられます。
C.はエルダー・レイリー異常症にみられたもので、好中球に暗紫色に染まる粗大な顆粒を認め、常染色
体劣性遺伝とされ、ヒアルロニダーゼなど酵素異常のために全身組織に酸性ムコ多糖類が沈着する病態に
おいてみられるといわれます。本症は非常に稀であることから、外国のアトラスより引用し紹介しました。
中毒性顆粒に比べ顆粒は大きさや量もかなり多いようです。
(阿南建一など:白血球:ベーシック形態検査.Medical Technology.1988)
( A victor Hoffbrand John E Pettit:Clinical Hematology.1994)
【正解】
【 形態所見 】 A:4. B:3. C:2.
【 考えられる疾患 】 A:3. B:2. C:4.
【正解率】
【 形態所見 】 A:90% B:100% C:100%
【 考えられる疾患 】 A:90% B:90% C:90%
形態マガジンTOPへ戻る
「症例16 解答と解説 」 を見る→